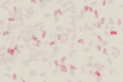

2011
2013
2009
2010
2017
2014
2012
2008
2016
2015
2007
2006
2006
2005
2004
2003
2001
2000
Lautgemalte Bilder
Christine Pierach

Das Mädchen, das ich liebe...
Luderer Ostner
Eine Seemans-Liebe
Gabriele Blachnik
Zuschriften
„Ringen um Leichtigkeit“
Michaela Resch PNP
„In drei Silben die ganze Welt“
Livia Takács
Burghauser Anzeiger
Die Schwärze der Nacht
Christian Muggenthaler
„Kunst an der Grenze“
Ines Kohl - Landshuter Zeitung
70 Jahre Paradies
Chr. Muggenthaler LZ
„Das geheimste Buch der Messe“
PNP Raimund Meisenberger
„Eine Chiffre des Lebens“
Michaela Schabel MZ
„Auftritt dea Shantychors“
Dingolfinger Anzeiger
Anton Kirchmair - Portrait
Passauer Kunst Blätter
„Anton alles andere als...“
Landshuter Wochenblatt
Ein Mann ein Buch
Christopher Schmidt - SZ
Ein Seemann im Bayerischen Wald
Sandra Wiest - BR
ein Baum mit vielen Ästen

Spitz auf Knopf - Vorankündung
G. Morgenroth - Traunst. Tagbl.
Spitz auf Knopf
G. Morgenroth - Traunst. Tagbl.
„Zwischen Sein und Schein“
Blachnik PNP
Gegensätzl. Kräfte
G. Morgenroth - OVB
Die Kunst des Wesentlichen
Michaela Schabel PNP
„Spitz auf Knopf“
Ines Kohl - LZ
Tara - Über d. Stand d. Dinge Eröffnungsrede
Dr. Franz Niehoff
„Toni Kirchmair überrascht“
Michaela Schabel MZ
Tara, eine Ausst. mit Gewicht
wil - Straubinger Tagblatt

Anton Kirchmair - Portrait
Passauer Kunst Blätter
Quer durch die Disziplinen
A. Humpeneder - LZ
Berühren streng verboten
Georgine Fisch - PNP
Holzkohle mit erot. Schwüngen
Gabr. Mayer MZ
„So schwarz wie Ebenholz“
S.Wolke - Der neue Tag
A: Kirchmair Block I-X
Ines Kohl - Lichtung
Eröffnungsrede
Dr. Gabler MMK Passau
Sisyphus im 5. Durchgang
Salzkammergut Rundschau
So schwarz wie Ebenholz
Ines Kohl - LZ
Kirchmairs durchglühte Hölzer
Dr. Helmut Wagner - LZ
„Holz in der Hipphalle“
PNP

Kunst so schwarz wie Ebenholz
S. Wolke - Der neue Tag
Eröffnungrede
a Cennino Cennini
Anke Humpeneder



„Der letzte Köhler“
Anke Humpeneder
Begegnung mit Anton Kirchmair
Finnissagerede - Riki
Eine Halle f.d.Kunst
Maria Eliskasis
Passauer Kunstblätter
Holz in der Hip
phalle

Liebeserklärung in Schwarz und Grau
FÖ - SZ
„Schweres schwebed gemacht“
Dr. St. Rammer - PNP

Buchenstäbe himmerlwärts
Anke Humpeneder - Lichtung
Möblierung des Raums
Anmerkungen zur Installation 3
Dr. Franz Niehoff
Sprechen über den Menschen
Anke Humpeneder - LZ
Mit aller Kraft zur Leichtigkeit
Dr. Marion Bornscheuer
Der Gliedermann
Anke Humpeneder
Die got. Architektur u. d. Wald
Dr. Henning Ritter
Spielerische Distanz
Anmerkungen zur Installation 2
Dr. Franz Niehoff - LZ


Zeichnung und Druckgraphik
Bezirk Landshut
Bionik: Die Natur als Lehrerin
Anke Humpeneder - LZ
Ruhiger geworden
Anke Humpeneder - LZ
Schöpfung aus Chaos
Michaela Schabel - PNP
Lineare Freiheiten
Faltblatt
Anke Humpeneder
Materialkrümmung
Dr. Helmut Kronthaler - MZ
Mut zur Muße
Anmerkungen zur Installation 4
Königl Andrea - LZ
Eine Verbeugung z. Abschied
Anke Humpeneder - LZ
Zeichnen im Raum
Dr. Helmut Kronthaler - LZ
Eröffnungsrede
Anke Humpeneder - LZ

Liebe auf den 2. Blick
Königl

Ballastabwurf
Dr. Franz Niehoff
Anmerkungen zur Installation 1
Dr. Franz Niehoff - LZ


Weisheit in den Wäldern
Anke Humpeneder - LZ
Linienspiele
Anke Humpeneder
„In den Buchen“
Kleindorfer Marx
Aus dem Fokus
Anke Humpeneder - LZ
Malerische Verschattung
Marita Pletter - PNP
Zeichnung: Seele meiner Arbeit
Sparkassenzentrale
Regensburg
Leicht wie Gedanke
Anke Humpeneder - Lichtung
Wieder sensibler werden
D.v.Klitzing - PNP
Gebrauchsanweisung
Neue Galerie Landshut
Klare Schlichtheit
Nike Sauerwald
Grenzen um und in uns
Rammer PNP
Durch die Bilder sehen lernen
Zeichnungen und Holzschnitte

Laudatio Kubinhaus
Anke Humpeneder
Im Gegensatz zu Kubin
M. Oßberger - Rieder Umschau
Ganz neue Art v. Holzschnitt
MZ
Anton Kirchmair in Zwickledt
gfi-PNP
Kunst und Askese
Wagner - LZ
Mit leichtem Gepäck
Anke Humpeneder - LZ
Kulturaustausch
Anke Humpeneder - LZ
Nur Striche und doch Raum
Michaela Schabel
Die ganze Welt auf ein paar Linien reduziert
Ulrich Kelber - MZ
Die Kraft der Linie
Stefan rammer - PNP
Holz Schnitt Farbe
Eröffnungsrede
Stefan Huber
Der Blick aus der Zukunft
Ausstellungskatalog
Petra Noll
Wunderbare Leichtigkeit
Anke Humpeneder - LZ
Referenzschreiben
Aufnahme Radierverein
Dr. Andreas Kühne
Das Auge zum Himmel
Horst Hanske SZ
Harmonie des Spontanen
R. Gottfried - Neues Volksblatt

Scheinbare Flüchtigkeit der Skizze
Hanske Horst - SZ
Urnenwand Prot. Friedhof
Kirche und Kunst
Drei Silben
Dr. Arthur Bartle
Buchbesprechung Drei Silben
Dr Arthur Bartle
Laudatio
Dr. Josefine Gabler
Tara
Adolf Hofstetter



















1999 – 1978

Ich möchte mich bei allen bedanken, den Autoren, den Fotografen, den Galeristen, den Museen, den Besuchern meiner Ausstellungen und all denen, die mir bei meiner Arbeit mit Rat und Tat zur Seite gestanden sind.
Ich möchte mich bei allen bedanken, den Autoren, den Fotografen, den Galeristen, den Museen, den Besuchern meiner Ausstellungen und all denen, die mir bei meiner Arbeit mit Rat und Tat zur Seite gestanden sind.

1978 – 1999
Michaela Schabel
Landshut Aktuell
Martin ortmeier
Passauer Kunstblätter



















































